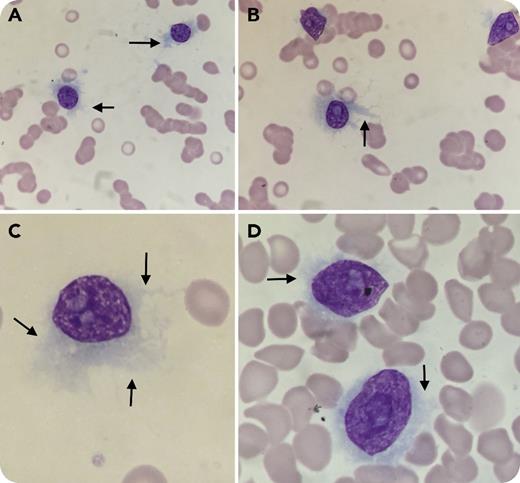
A 76-year-old woman presented with pallor, fatigability, and body ache. The complete blood count showed hemoglobin 6.7 g/dL, leukocytes 6.5 × 109/L, lymphocytes 5.1 × 109/L, and platelets 11 × 109/L. Peripheral blood smears revealed medium-to-large atypical lymphoid cells (82%) with hairy and shredded cytoplasmic projections (arrows) and dispersed chromatin with prominent nucleoli resembling variant hairy cell leukemia (vHCL) (panels A-D; May-Grünwald Giemsa stain, original magnification ×1000). On flow cytometry, the side scatter/CD19 gated cell cluster (78%) lacked expression of CD11c, CD23, CD103, or CD123 excluding vHCL but expressed CD38 (strong), CD138 and CD56 (coexpressed), and λ light-chain restriction. Serum protein electrophoresis and immunofixation revealed M-component immunoglobulin G λ. The overall features were consistent with plasma cell leukemia (PCL). / Plasma cells do occasionally show hairy and shredded cytoplasm, but they do not usually constitute the entire plasma cell population as in this case. However, the morphology of plasma cells is often misleading and is not the only diagnostic criterion for PCL. This case highlights the rationale of PCL being taken as a differential diagnosis when one sees typical morphology of vHCL. Inclusion of plasma cell markers in the immunophenotyping panel for B-cell lymphomas with vHCL morphology is thus recommended.

A 76-year-old woman presented with pallor, fatigability, and body ache. The complete blood count showed hemoglobin 6.7 g/dL, leukocytes 6.5 × 109/L, lymphocytes 5.1 × 109/L, and platelets 11 × 109/L. Peripheral blood smears revealed medium-to-large atypical lymphoid cells (82%) with hairy and shredded cytoplasmic projections (arrows) and dispersed chromatin with prominent nucleoli resembling variant hairy cell leukemia (vHCL) (panels A-D; May-Grünwald Giemsa stain, original magnification ×1000). On flow cytometry, the side scatter/CD19 gated cell cluster (78%) lacked expression of CD11c, CD23, CD103, or CD123 excluding vHCL but expressed CD38 (strong), CD138 and CD56 (coexpressed), and λ light-chain restriction. Serum protein electrophoresis and immunofixation revealed M-component immunoglobulin G λ. The overall features were consistent with plasma cell leukemia (PCL).
Plasma cells do occasionally show hairy and shredded cytoplasm, but they do not usually constitute the entire plasma cell population as in this case. However, the morphology of plasma cells is often misleading and is not the only diagnostic criterion for PCL. This case highlights the rationale of PCL being taken as a differential diagnosis when one sees typical morphology of vHCL. Inclusion of plasma cell markers in the immunophenotyping panel for B-cell lymphomas with vHCL morphology is thus recommended.
A 76-year-old woman presented with pallor, fatigability, and body ache. The complete blood count showed hemoglobin 6.7 g/dL, leukocytes 6.5 × 109/L, lymphocytes 5.1 × 109/L, and platelets 11 × 109/L. Peripheral blood smears revealed medium-to-large atypical lymphoid cells (82%) with hairy and shredded cytoplasmic projections (arrows) and dispersed chromatin with prominent nucleoli resembling variant hairy cell leukemia (vHCL) (panels A-D; May-Grünwald Giemsa stain, original magnification ×1000). On flow cytometry, the side scatter/CD19 gated cell cluster (78%) lacked expression of CD11c, CD23, CD103, or CD123 excluding vHCL but expressed CD38 (strong), CD138 and CD56 (coexpressed), and λ light-chain restriction. Serum protein electrophoresis and immunofixation revealed M-component immunoglobulin G λ. The overall features were consistent with plasma cell leukemia (PCL).
Plasma cells do occasionally show hairy and shredded cytoplasm, but they do not usually constitute the entire plasma cell population as in this case. However, the morphology of plasma cells is often misleading and is not the only diagnostic criterion for PCL. This case highlights the rationale of PCL being taken as a differential diagnosis when one sees typical morphology of vHCL. Inclusion of plasma cell markers in the immunophenotyping panel for B-cell lymphomas with vHCL morphology is thus recommended.
For additional images, visit the ASH Image Bank, a reference and teaching tool that is continually updated with new atlas and case study images. For more information, visit http://imagebank.hematology.org.

This feature is available to Subscribers Only
Sign In or Create an Account Close Modal